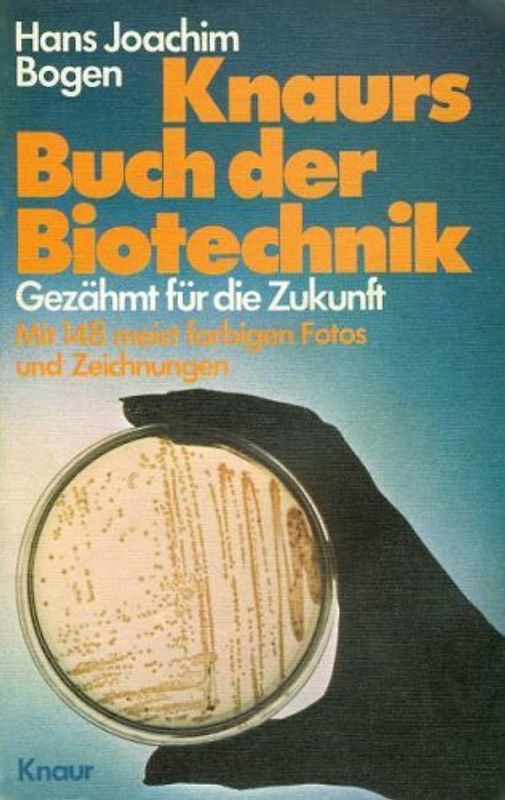
Gezähmt für die Zukunft. Leistungen und Perspektiven der Biotechnik - Hans Joachim Bogen

Handgeprüfte Gebrauchtware
Bis zu 50 % günstiger als neu
Der Umwelt zuliebe
Handgeprüfte Gebrauchtware
Bis zu 50 % günstiger als neu
Der Umwelt zuliebe
Hersteller: Verlagsgruppe Droemer Knaur GmbH & Co. KG, Maria-Luiko-Straße 54, München, Deutschland, 80636, produktsicherheit@droemer-knaur.de, Verlagsgruppe Droemer Knaur GmbH & Co. KG
